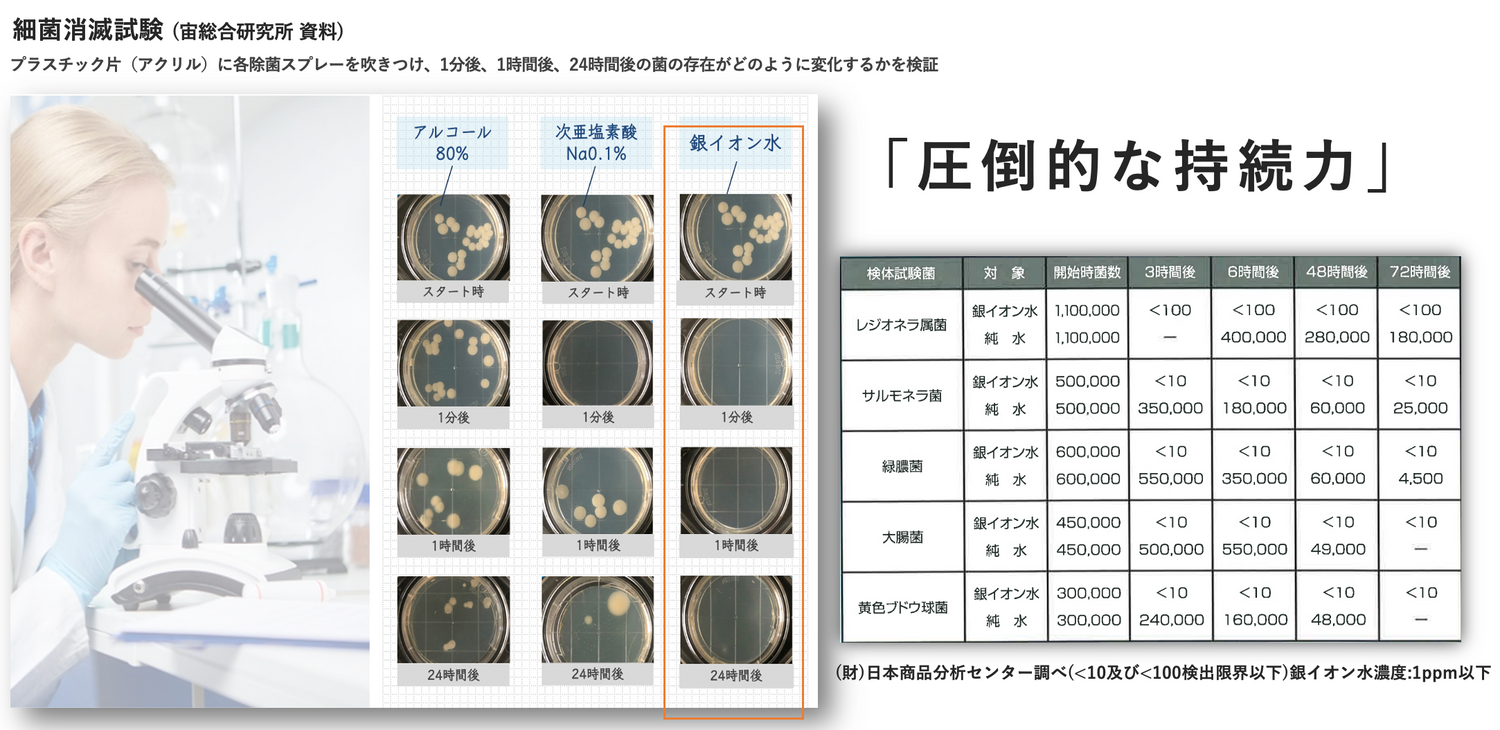

PICK UP-mögen.デザイン-
PICK UP -オリジナルデザイン-


Original design
オリジナルデザイン制作。
貰って喜ばれるギフトの新定番。ちょっとしたプレゼントや出産祝いにも。
自分の名前が入っていると...やっぱり嬉しい。大切な人へのサプライズにも。

Bottle type
帰宅したらまず衣服にシュッ。
毎回洗濯できない大切なお洋服やぬいぐるみなどに除菌&消臭を。
お手軽なサイズでリビングや車内でも大活躍。家具やソファーなどを傷めません。
ペット周りや普段のお掃除はこれ1本で。

Mini bottle type
気になる時にサッと消臭。
寝室やデスク周りなどはもちろん、汗・体臭・靴下のニオイが気になる人は1本カバンにいれておくことで、サッと防臭&消臭対策に。
どのシチュエーションでも大活躍の1本。

Box type
除菌剤ってどこに置けばいいのだろう。
洗練されたデザインで、誰にでもどんなインテリアにも溶け込み景観を邪魔しません。
玄関・キッチン・リビングに置きたいお洒落なタイプ。除菌剤も一つのインテリアに。
Review
-
mögen. 20mlギフト<3個set>★★★★★
商品はこちらパケがとにかくオシャレ♡
コンパクトで持ち運び便利!
スプレーのパケに名前を入れることも出来るので、出産祝いやプチギフトにもとっても素敵な商品だと思います。 何よりパケの見た目が可愛く、 オシャレで、持ち運びに便利な超薄型のカード型なので、 ハンカチやティッシュを入れる感覚で洋服のポケットに入れておいたり、小さなポシェットのポケット部分に入れても、かさばらずにとっても便利でした! アルコール消毒だと刺激がつよく、ヒリヒリしたりすることも多いですが、銀イオンスプレーはお肌にも優しくって、荒れないのも魅力的です。 親子共々、外出先で手軽に使えてかつしっかりとした抗菌・抗ウイルス効果があるのはとっても嬉しいので、これからも愛用させていただきます♡
-
mögen. 300mlボトルスプレー(basic) ★★★★★
商品はこちらもっと早く知りたかった!
我が家には中型犬が2匹と猫1匹います。 他製品の消臭剤を何年も使用していたんですが、友人からすすめられて使ってみたらびっくり!一瞬で本当に驚くくらいペットのおしっこの臭いが消えます!効果があるのに、アルコールと違ってペットが舐めても安全だと思うとこの価格には納得です!リピート決定です!
-
mögen. 20mlカード型 ホワイト(basic) ★★★★★
商品はこちら銀イオンのすごさ
薬局で花粉に効く!とうたってる銀イオンスプレーを何個も試したけど全く効かず、、、 友人に勧められたこちらを購入し マスク、顔、髪、とこまめにスプレーすると かなり楽になり手放せない存在になりました。 市販の物より少し高いけど濃度の高さに納得。 携帯用にカード型、自宅用にスプレーを常備してます。
ABOUT US

ABOUT mögen
-daily necessities
mögen.(モゲン)には、
ドイツ語で「好き」や「好きになる」という意味があります。
除菌を繰り返した手肌や金属アレルギーの方、赤ちゃんからペットまで
みんなが使える「やさしさ」と、
データに裏付けされた除菌・抗菌・消臭という確かな効果を併せ持つのが、
高品質銀イオンmögen. ”daily necessities”です。
OUR STORY
POINT
-
「アルコール・次亜塩素酸と比較しても明確な銀イオンの効果・効能」
一般的なアルコールや次亜塩素酸は約1時間後には菌が繁殖しますが、銀イオン水は24時間菌の繁殖を抑え、即効性・持続性ともに優れている事が証明されています。
スライド画像のウィルスの他にも米国アリゾナ大学など多くの分献でもインフルエンザウィルス・O-157・MRSA・肺炎かん菌・ビブリオ菌・真菌類(カンジダ・水虫菌など)など(一部抜粋)ほとんどの微生物に除菌・抗菌効果が認められています。
-
「8つのフリーをお約束します」
成分は99.99%の純銀と純水とリンゴ酸のみの食品添加物だけでつくられているので赤ちゃんや肌の弱い人だれにとっても安心・安全なスプレーです。
①アルコールフリー②次亜塩素酸フリー③化学物質フリー④保存料フリー⑤無着色⑥無香料⑦パラベンフリー⑧界面活性剤フリー
-
「除菌だけじゃない、幅広い使用用途」
<除菌・消臭・花粉・黄砂・ハウスダスト・食中毒対策に>
まな板/食器/冷蔵庫の中/ペット用品/赤ちゃん用品/おむつ/帽子/加湿器/ドアノブ/リモコン/おしっこがついた布/寝具/靴/靴下/汗のついた衣服/家具/メガネ/PC/車内/浴室etc..
刺激性がない中性のため、革製品・木製品も変色させたり傷めたりせず状態を維持することができます。(個体差もあるのでご使用前は一部試してからご使用ください)